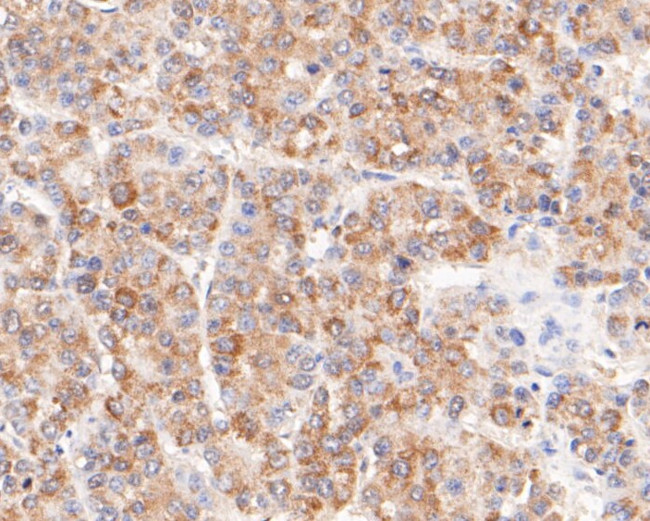
FH Antibody in Immunohistochemistry (Paraffin) (IHC (P))

Search
Huabio
FH Polyclonal Antibody
{{$productOrderCtrl.translations['antibody.pdp.commerceCard.promotion.promotions']}}
{{$productOrderCtrl.translations['antibody.pdp.commerceCard.promotion.viewpromo']}}
{{$productOrderCtrl.translations['antibody.pdp.commerceCard.promotion.promocode']}}: {{promo.promoCode}} {{promo.promoTitle}} {{promo.promoDescription}}. {{$productOrderCtrl.translations['antibody.pdp.commerceCard.promotion.learnmore']}}
图: 1 / 5
FH Antibody (ER1901-10) in IHC (P)





产品信息
ER1901-10
种属反应
宿主/亚型
分类
类型
抗原
偶联物
形式
浓度
规格
纯化类型
保存液
内含物
保存条件
运输条件
靶标信息
The protein encoded by this gene is an enzymatic component of the tricarboxylic acid cycle, or Krebs cycle, and catalyzes the formation of L-malate from fumarate. It exists in both a cytosolic form and an N-terminal extended form, differing only in the translation start site used. The N-terminal extended form is targeted to the mitochondrion, where the removal of the extension generates the same form as in the cytoplasm. It is similar to some thermostable class II fumarases and functions as a homotetramer. Mutations in this gene can cause fumarase deficiency and lead to progressive encephalopathy.
仅用于科研。不用于诊断过程。未经明确授权不得转售。
篇参考文献 (0)
生物信息学
蛋白别名: EF-3; epididymis secretory sperm binding protein; Fumarase; fumarase precursor (EC 4.2.1.2); fumarate hydratase 1; Fumarate hydratase, mitochondrial; unnamed protein product
基因别名: FH; Fh-1; Fh1; FMRD; HLRCC; HsFH; LRCC; MCL; MCUL1
UniProt ID: (Human) P07954, (Rat) P14408, (Mouse) P97807
Entrez Gene ID: (Human) 2271, (Rat) 24368, (Mouse) 14194